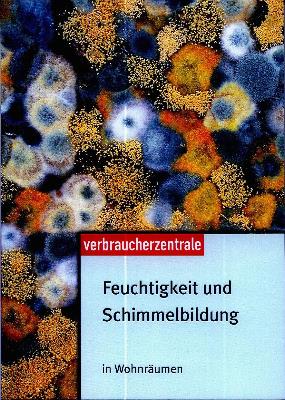
Buchrezension_Feuchtigkeit-und-Schimmelbildung

Feuchtigkeit und Schimmelbildung – Tipps zur Bekämpfung und Prophylaxe
Schimmelpilz kann nicht nur massive Schäden am Gebäude anrichten, sondern sich auch negativ auf Raumklima und Gesundheit auswirken – eine schnelle Bekämpfung oder frühzeitige Vorsorge ist hierbei unerlässlich. Hilfe bei Vermeidung oder Bekämpfung des tückischen Plagegeistes bietet der Ratgeber „Feuchtigkeit und Schimmelbildung“. Der Ratgeber erläutert die Ursachen, die zu Schäden führen können, informiert über Risiken verschiedener Baumaterialien und gibt geeignete Tipps zur Abhilfe. Ein Überblick über die aktuelle Rechtsprechung und eine mögliche Entschädigung im Schadensfall runden die hilfreiche Basis-Lektüre ab.Der Ratgeber ist für 7,90 Euro in jeder Beratungsstelle der Verbraucherzentrale NRW erhältlich. Zuzüglich für 2,50 Euro Porto und Versand kann das Buch auch bestellt werden.
Schimmelpilz kann nicht nur massive Schäden am Gebäude anrichten, sondern sich auch negativ auf Raumklima und Gesundheit auswirken – eine schnelle Bekämpfung oder frühzeitige Vorsorge ist hierbei unerlässlich. Hilfe bei Vermeidung oder Bekämpfung des tückischen Plagegeistes bietet der Ratgeber „Feuchtigkeit und Schimmelbildung“. Der Ratgeber erläutert die Ursachen, die zu Schäden führen können, informiert über Risiken verschiedener Baumaterialien und gibt geeignete Tipps zur Abhilfe. Ein Überblick über die aktuelle Rechtsprechung und eine mögliche Entschädigung im Schadensfall runden die hilfreiche Basis-Lektüre ab.Der Ratgeber ist für 7,90 Euro in jeder Beratungsstelle der Verbraucherzentrale NRW erhältlich. Zuzüglich für 2,50 Euro Porto und Versand kann das Buch auch bestellt werden.
Bestellmöglichkeiten:
Verbraucherzentrale NRW, Versandservice, Adersstr. 78, 40215 Düsseldorf
Tel: (02 11) 38 09-555, Fax: (02 11) 38 09-235,
E-Mail: publikationen@vz-nrw.de, Internet: www.vz-ratgeber.de

 Pflegeliebling
Pflegeliebling Fides Humanitas Stiftung
Fides Humanitas Stiftung 5Stars Kindertagespflege
5Stars Kindertagespflege Druckmaxx
Druckmaxx Konzeptschmied
Konzeptschmied Missionarische Gefährdetenhilfe Wendepunkt e.V.
Missionarische Gefährdetenhilfe Wendepunkt e.V. Glücksfischer Lübeck
Glücksfischer Lübeck Kontrapunkt.Bibel.e.V
Kontrapunkt.Bibel.e.V